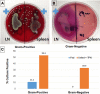

Intestinal epithelial cell apoptosis and loss of barrier function in the setting of altered microbiota with enteral nutrient deprivation
- PMID: 24392360
- PMCID: PMC3870295
- DOI: 10.3389/fcimb.2013.00105
Intestinal epithelial cell apoptosis and loss of barrier function in the setting of altered microbiota with enteral nutrient deprivation
Abstract
Total parenteral nutrition (TPN), a commonly used treatment for patients who cannot receive enteral nutrition, is associated with significant septic complications due in part to a loss of epithelial barrier function (EBF). While the underlying mechanisms of TPN-related epithelial changes are poorly understood, a mouse model of TPN-dependence has helped identify several contributing factors. Enteral deprivation leads to a shift in intestinal microbiota to predominantly Gram-negative Proteobacteria. This is associated with an increase in expression of proinflammatory cytokines within the mucosa, including interferon-γ and tumor necrosis factor-α. A concomitant loss of epithelial growth factors leads to a decrease in epithelial cell proliferation and increased apoptosis. The resulting loss of epithelial tight junction proteins contributes to EBF dysfunction. These mechanisms identify potential strategies of protecting against TPN-related complications, such as modification of luminal bacteria, blockade of proinflammatory cytokines, or growth factor replacement.
Keywords: epithelial barrier function; epithelial call proliferation; epithelial cell apoptosis; microbiome; parenteral nutrition; small intestine.
Figures

Similar articles
-
Tight Junction Ultrastructure Alterations in a Mouse Model of Enteral Nutrient Deprivation.Dig Dis Sci. 2016 Jun;61(6):1524-33. doi: 10.1007/s10620-015-3991-3. Epub 2015 Dec 21. Dig Dis Sci. 2016. PMID: 26685910
-
Homeostasis alteration within small intestinal mucosa after acute enteral refeeding in total parenteral nutrition mouse model.Am J Physiol Gastrointest Liver Physiol. 2016 Feb 15;310(4):G273-84. doi: 10.1152/ajpgi.00335.2015. Epub 2015 Dec 3. Am J Physiol Gastrointest Liver Physiol. 2016. PMID: 26635320 Free PMC article.
-
Tumour necrosis factor--induced loss of intestinal barrier function requires TNFR1 and TNFR2 signalling in a mouse model of total parenteral nutrition.J Physiol. 2013 Aug 1;591(15):3709-23. doi: 10.1113/jphysiol.2013.253518. Epub 2013 Jun 10. J Physiol. 2013. PMID: 23753529 Free PMC article.
-
Mechanisms regulating intestinal barrier integrity and its pathological implications.Exp Mol Med. 2018 Aug 16;50(8):1-9. doi: 10.1038/s12276-018-0126-x. Exp Mol Med. 2018. PMID: 30115904 Free PMC article. Review.
-
Gut Microbiota Disorder, Gut Epithelial and Blood-Brain Barrier Dysfunctions in Etiopathogenesis of Dementia: Molecular Mechanisms and Signaling Pathways.Neuromolecular Med. 2019 Sep;21(3):205-226. doi: 10.1007/s12017-019-08547-5. Epub 2019 May 21. Neuromolecular Med. 2019. PMID: 31115795 Review.
Cited by
-
Risk factors for candidemia: a prospective matched case-control study.Crit Care. 2020 Mar 18;24(1):109. doi: 10.1186/s13054-020-2766-1. Crit Care. 2020. PMID: 32188500 Free PMC article.
-
The enteric nervous system neuropeptide, bombesin, reverses innate immune impairments during parenteral nutrition.Ann Surg. 2014 Sep;260(3):432-43; discussion 443-4. doi: 10.1097/SLA.0000000000000871. Ann Surg. 2014. PMID: 25115419 Free PMC article.
-
Review of parenteral nutrition-associated liver disease.Clin Exp Hepatol. 2020 Jun;6(2):65-73. doi: 10.5114/ceh.2019.95528. Epub 2020 May 21. Clin Exp Hepatol. 2020. PMID: 32728621 Free PMC article. Review.
-
Diet-dependent, microbiota-independent regulation of IL-10-producing lamina propria macrophages in the small intestine.Sci Rep. 2016 Jun 15;6:27634. doi: 10.1038/srep27634. Sci Rep. 2016. PMID: 27302484 Free PMC article.
-
The Effects of Zinc Oxide Nanoparticles on Antioxidation, Inflammation, Tight Junction Integrity, and Apoptosis in Heat-Stressed Bovine Intestinal Epithelial Cells In Vitro.Biol Trace Elem Res. 2024 May;202(5):2042-2051. doi: 10.1007/s12011-023-03826-6. Epub 2023 Aug 30. Biol Trace Elem Res. 2024. PMID: 37648935
References
-
- Alverdy J. C., Aoys E., Moss G. S. (1988). Total parenteral nutrition promotes bacterial translocation from the gut. Surgery 104, 185–190 - PubMed
Publication types
MeSH terms
Substances
LinkOut - more resources
Full Text Sources
Other Literature Sources
Medical
Research Materials
Miscellaneous

